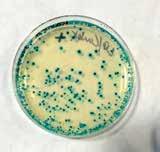

4
Taking Center Stage
Biotech: Bridging Education and Industry
Published at PRS 16 Math at PRS
Here Comes the Sun FROM THE RIDGE | WINTER 2024
6
12
18

For years I have been telling Pacific Ridge School families that one of the aspects I like most about our program is how it can help so many different kinds of adolescents discover more about who they are, who they want to be, what they want to do next, and prepare them for the known (and unknown) paths ahead.
REFLECTING ON THE JOURNEY OF DISCOVERY
Dr. Bob Ogle, Head of School
I see it every year. I feel it in the depth, diversity, and complexity of our program, and I hear about it from families. However, this year, with three to four months left in my tenure as a Pacific Ridge School parent, I can tell you that I have witnessed this profound discovery not just as a school leader, but as a PRS parent.
You see, if all goes well (yes, I am a little superstitious!), on June 13 I will have the honor of handing my son, and the entire class of 2024, a high school diploma. That day will mark the last of a nine-year journey for me and my family – a journey for which I will forever be grateful. Why? Because like so many parents, I have two very different children, and they have both found a home, a path, and a sense of their young selves on this campus. How did that happen? How does it happen each year at Pacific Ridge for young people who have very different goals, plans, strengths, and desires? As I said above, I believe it is in the depth, diversity, and complexity of our program.
Starting in middle school, the Pacific Ridge School program asks young
people not just to memorize and repeat, but to listen, to hear, to synthesize, and to problem solve. We ask our students to dig deep on complex issues. In addition, our program is purposefully diverse. In middle school, students take part not just in math, English, history, science, and world language, but they also take part in clubs, service learning, multiple athletic teams, at least five disciplines in the arts, and they travel with their teachers and classmates each year. I like to say that “all our middle school students dance and weld,” because they do, and because that illustrative example represents a unique array of programming at Pacific Ridge –an array of programming that matters.
In middle school, I watched both my children try out new sports, push themselves into new areas of performing and visual arts, interact with communities they had never seen before, and grow as young people during those incredibly formative early teenage years.
Then, in high school, our students take the exposure they gained in middle school, and begin to make choices.
2 VIEW FROM THE RIDGE
They choose year-long arts courses and service learning groups. They become more specialized in athletics, and they take part in grade-level projects that help them identify and articulate a budding sense of self. The myth (or muse) project combined with orations and end-ofthe-year travel in the wilderness creates a series of coming-of-age moments at Pacific Ridge that both define who they are now and create variable paths for the future. A future that leads to greater choice in courses, co-curriculars, travel, and, ultimately college.
My children both carried passions they brought to PRS from their primary school years through senior year, they both dropped parts of their lives they thought were important to them before they arrived at PRS, and they both picked up new passions as a result of the exposure and depth in our program. And, they both took very different paths through Pacific Ridge School.
For so many reasons, I am incredibly grateful for the honor of sharing a school campus with my children for nine years. However, I am mostly proud of the young adults they have become – they



both advocate for themselves, work hard, seek out interesting and caring people, new experiences, and familiar traditions, and, they enjoy completely different kinds of activities. All traits they developed during their time in the Pacific Ridge School program.

Winter 2024 3














4 VIEW FROM THE RIDGE





TAKING CENTER STAGE
The school year kicked off with two captivating productions from the Pacific Ridge Arts Department.
Sixth graders came together to put on Alice’s Adventures in Wonderland by Rachel Teagle. The adaptation of this beloved classic showcases the wayfinder’s journey and the power of imagination as Alice discovers that confidence and wit are powerful tools to get her through Wonderland and life – major themes of the sixthgrade experience at Pacific Ridge.

The beginning of this year also brought the Upper School production of Blithe Spirit by Noël Coward. The play is about a remarried, fussy, cantankerous novelist named Charles Condomine who finds himself haunted (literally) by the ghost of his late first wife.








Winter 2024 5
Bridging Education and Industry:
DR. BURCKIN BRINGS NEW BIOTECH COURSE TO CAMPUS
Biotechnology will impact us all more and more in the coming years, and we live in one of the largest biotech hubs in the world, so it’s relevant and it’s local! My hope is that this is a great addition to our science program that captures the interest of a variety of students.
–Dr. Burckin

There is so much research and news about the field of biotechnology, and specifically innovation in medicine with genetics, which I learned about in my Science 10 class. Ever since then, I have wanted to learn more about the processes behind innovation in biology in general, which prompted me to take this course.
–Samira Seendripu ’25


The Pacific Ridge science program emphasizes an integrated approach to help students realize the interconnected nature of science and the impact of science and technology on society.
Grades six through 10 students explore science through a phenomena-based inquiry and projectoriented curriculum that weaves together life, physical, earth, space, and computer science, much of it rooted in design and engineering practices. The science program fosters curious students who engage in investigation and collaboration of the many facets of science.
And as science continues to evolve, so too do Pacific Ridge School’s offerings. This year, Dr. Todd Burckin brought a new elective for juniors and seniors interested in further exploring the connection between science and technology.

6 VIEW FROM THE RIDGE


This course allows students to explore the many fields connected to biotechnology. Earlier this year students grew their own Wisconsin Fast Plants to mimic what many are researching to make plants and organisms more suitable and sustainable in different environments.
Students in the class are also genetically engineering bacteria in the Innovation Center’s Biotechnology Lab, expanding on what students learn regarding DNA in Science 10. Recently, biotech students joined AP Psychology students during a presentation from guest speaker, Sydney Smith, a Ph.D. candidate in computational neuroscience, specializing in neural signal analysis and researching how brain waves may change in patients receiving treatment for depression.
We read an article about how DNA can now be pulled from thin air, and talked about the morals behind this, and if it was too much of a privacy concern with advanced technology becoming more accessible to the public. It is interesting to me how technology can be seen as both an asset and possible concern.
– Stella Witz ’24
Along with the hands-on learning of what is possible in biotechnology, the students also discuss the ethics of science and research through Harkness conversations around a range of topics from reproductive cloning to privacy issues of genomic data. Science is founded on exploration of many different viewpoints, and Dr. Burckin hopes to use the Biotechnology course to prepare students for the interconnected world of science and technology.



Winter 2024 7
SUPPORTING IMPACTFUL OPPORTUNITY FOR FIRST-GEN SCHOLARS
Pacific Ridge Opportunity Scholars have matriculated to the following schools over the past decade:













Every year, our school community proudly invests in the academic journeys of first-generation, college-bound students who have demonstrated academic excellence and financial need. The Opportunity Scholarship program, rooted in our commitment to diversity, equity, and inclusion, celebrates each student’s unique identity and experience in our community. Since its inception in 2013, the program has evolved from supporting a single scholar to now providing full-tuition scholarships to up to 10 students each year.
With the generous support of the Pacific Ridge community, we have graduated 18 scholars through the PRS Opportunity Scholarship program.
These students bring diverse cultural experiences that enrich our school’s tapestry, fostering a
learning environment where every student's background is celebrated and valued. By nurturing a diverse group of future leaders, our program contributes to a more equitable and dynamic school community, enriching the educational experience for all.
For more information about supporting the Opportunity Scholarship program, please contact Allissa Thompson, Associate Director of Annual Giving and Major Gifts at 760-448-9883 or athompson@pacificridge.org.
Your gift to this impactful program is an investment in the future of our school community.

Pacific Ridge is not just about teaching, but about nurturing diverse perspectives and creating a collaborative world. The Opportunity Scholarship underscores this belief. We believe our family’s support of the Opportunity Scholarship is an important investment in the future. We give because we have been given so much.
- Horton Family
Catching Up
WITH VALENTINA WATSON ‘21
Valentina attended Pacific Ridge from ninth through 12th grade and is currently studying computer science and software engineering at Harvey Mudd College.
In what ways did PRS prepare you for college, career, and a purposeful life?
The Innovation Center is home to many of my technological creative endeavors. Being a part of the Pyrobots Robotics team sparked my love of engineering and technology while the Biotech Lab furthered my love of the intersection between humanity and science. What advice would you give to students who earn placement in the Opportunity Scholarship program? I would tell them to utilize all of the resources available to them. High school was essential in my discovery of what I wanted to do afterward and the scholarship gives you so much room to do that.
What should people know about the Opportunity Scholarship program?
I wouldn’t be where I am today without the Opportunity Scholarship program! The mentorship and guidance I received from the staff and faculty were instrumental in my journey from high school to university, empowering me to forge my path. While I was in high school, the Opportunity Scholarship helped me feel like I belonged while attending a school beyond what I thought possible. There is something so nerve-wracking about feeling like you have to fit in with a different demographic than what you grew up in, but because of the program, those feelings never stopped me from feeling a part of the community.

The Opportunity Scholarship gave me access to a supportive community and resources that prepared me to exceed expectations post high school.
8 VIEW FROM THE RIDGE
ALUMNI HIGHLIGHT: A FAMILY OF FIREBIRDS
–The Bundogjis
The Bundogji family has graduated three siblings from Pacific Ridge, Nour ‘11, Abdullah ‘13, and Danna ‘23. Nour is currently an ophthalmic fellow in Chicago, Illinois, after attending the University of Arizona College of Medicine – Phoenix, Abudallah works with Boeing as a propulsion engineer, and Danna is currently studying computer science at San Diego State University.

HOW HAS PRS PREPARED YOU FOR WHAT YOU ARE DOING NOW?
Danna: Participating in service learning groups and clubs at PRS was instrumental. These experiences laid the foundation for my leadership journey, providing opportunities to cultivate skills and build relationships with both peers and staff members. The exposure to varied networking environments equipped me with the confidence to navigate diverse settings. Additionally, with the support of the PRS community, organizing a traditional dance performance on campus fueled my passion for educating others about my Middle Eastern culture.
Abdullah: I'll be honest, PRS challenged me with curriculum that pushed me way past what I thought I could handle. But thanks to the awesome teachers and classmates who helped me figure out my learning style to do well in school, it made the college classes a lot easier. Combine that with the mix of service learning and all those extracurriculars opened up a perspective beyond STEM, giving me a taste of things that molded me beyond just my career.
DO YOU HAVE A FAVORITE PRS MEMORY?
Danna: Our 2022 trip to Barcelona! The school's exceptional organization of the trip, complete with visits to museums and other enriching activities, not only connected me with fellow students but also provided me with an immersive experience in the rich and unique culture of Spain.
Nour: From the end-of-the-year trips and the Odyssey trial to Gingerbread Breakfasts and the senior project, many memories stand out. I don't think I can choose one memory as my favorite. Not to sound cheesy, but the four years I spent at PRS is a favorite memory of mine. I look back at those years so fondly, especially since I had the opportunity to help create PRS traditions as the first graduating class
HOW DID HAVING A SIBLING AT PRS IMPACT YOUR EXPERIENCE?
Abdullah: It was nice having my older sister at PRS while I was there and it was crazy to think we both took a class together. Having my younger sister Danna attend in a way made me feel like I was still a part of the school hearing about her classes and experiences.
Nour: I feel lucky that I was able to experience PRS from three different perspectives. With Abdullah just two grades below me and then seeing how my sister, Danna, was able to make her own memories from these PRS traditions, eight short years later, it was a treat. I look forward to seeing how PRS traditions like the ninth grade orations or the faculty versus students field day continue.


DID YOU HAVE A FAVORITE CLASS OR HAVE A TEACHER THAT MADE A STRONG IMPACT ON YOU?
Danna: Mrs. Behr's AP Art History class not only fueled my passion for art history but also provided me with study techniques that I use in my undergraduate studies. Her encouragement played a pivotal role in shaping my artistic pursuits.
Nour: There isn't one teacher at PRS who did not have an impact on me. However, if I had to choose, I would say the dynamic and brilliant duo, Dr. Burkin and Ms. Wasserman. Much of my success in undergrad and medical school was in small part due to how they always reminded me to remain curious. They are both an inspiration to me! Thank you so much for challenging me to always remain inquisitive.
Winter 2024 9



SETTING THE STANDARD FIREBIRD GIRLS VOLLEYBALL AND THE IMPORTANCE OF TEAMWORK
This team was at another level. In a high school setting, kids don’t show up every day. But with this team, there was none of that. They all showed up. Even if someone was injured, they made sure they were at practice and at the games. There was commitment and care for the entire team. It was really special.
- Coach Jed Stotsenberg
The Pacific Ridge Girls Volleyball team had one of their strongest seasons, ranking 3rd in the Coastal Conference, soaring to the finals of CIF Regionals and causing an upset in the first game of CIF States, feats they credit to the commitment of their team.
Volleyball is a sport that requires a certain kind of dependability on
teammates. You cannot bump, set, and spike the ball yourself; you need your team. So it is no wonder that the connection and trust in a team is vital to the success of a season, and if you sat in the bleachers of a home volleyball game this year, you would have seen just how dedicated the PRS volleyball team is.
PRS volleyball is supportive and positive; it’s for everyone. It’s never just for yourself to get that kill or ace, or to get the crowd hyped up. Club focuses a lot on college recruiting and there can be competition within positions. But, at PRS, we play with the idea that we want everyone on the team to succeed. We play for each other, to be there for one another.
–Nikki ‘24
At the beginning of the season, the senior captains, Nikki Patton and Cam Bolane, who are both committed to play Division I collegiate volleyball next year, approached Coach Jed Stotsenberg with the desire to push the volleyball program further than they’ve gone before. “This was the year in the making,” Nikki explained, proud of her final season. They wanted to compete with Division 1 teams and play in a tougher league. The team petitioned for a tougher schedule and rose to the challenge, even placing 5th in the San Diego Classic Invitational and 9th in the Division 1 SoCal Invitational.
Coach Stotsenberg, who has been coaching now seniors Cam, Nikki, and Maizy since they began their PRS athletic careers, knew the team was ready to push themselves.
10 VIEW FROM THE RIDGE



The volleyball program begins each season at what they call “Day Zero,” going over goals and values to set the tone for the season. They discuss what it means to be PRS Volleyball and develop who they are as a team, what they stand for, and how to come back to that anytime they need.
As co-captain, Cam keeps her team values on a slip of paper in the back of her phone, referring to them as “Jed'isms”. One side lists the values and affirmations for the team and the other side shows what the team hopes to be known for – what the girls call the “Theys” of the team. If someone said, “They’re great at passing,” or “They can play in any environment,” the team would know they’re sticking to their values and showing up.
With a personal motto of “keep grinding,” when asked what advice


she would give to any student-athlete looking to continue their careers into college, Cam offered, “Be open to truth and criticism. You cannot always be the best player on the court. There’s always something to improve and there isn’t a point that you’ll reach and say ‘this is it.’ Focus on that 1% each day.”
Cam Bolane signed to play middle hitter for Yale and Nikki Patton signed as outside hitter for Marist College next year.
“PRS sports are extra special because of how many faculty are involved in coaching and supporting our teams. My coaching staff was greater than most college staff, and we would not be the team we were without this support,” said Stotsenberg.
Congratulations to all the players and coaches on a remarkable season.
THE THEYS”
Great passers
Ball is always in play
Everyone can score Offense is spread out
Great defense
Serve tough
Stay together
Accountable
Know needs
Move on Any environment
TEAM VALUES
Truth
Passion Belief Teamness
The Process
Feed the Wolf
E+R=Outcome
Prepare or Die
Control the
Controllables
Hype Number
All on the Floor


Winter 2024 11
Creating BRIGHT FUTURES


Pacific Ridge was honored in September for its unwavering commitment to education, empowerment, and partnership by the Escondido-based non-profit organization, A Step Beyond.
A creative youth development organization, A Step Beyond provides free after-school dance classes, academic support, and social services to students. The organization integrates arts and humanities to inspire creativity, critical learning, and life skills in young people. Pacific Ridge School has partnered with A Step Beyond over the past five years to help North County students create lasting relationships that will ensure our youth's academic and socialemotional development through middle school, high school, and beyond.
PUBLISHED AT PRS



Lucas Pierce ‘25
Lucas’s most recent project, “The Baseball Cap,” won the San Diego International Kids Film Festival and the Lake Travis Film Festival. The short advocates for the early diagnosis of dyslexia and highlights the skills people with dyslexia have in multiple areas including the arts.
“It is based on a true story about my younger brother who was diagnosed with dyslexia in third grade. I was inspired to create this film after witnessing my brother struggle in his early education prior to his diagnosis,” said Lucas. “After my brother was diagnosed with dyslexia, he was homeschooled by my mom using a completely different curriculum that was geared toward dyslexic students. I saw firsthand how much my brother improved following his diagnosis and after receiving the appropriate educational interventions.”
Yanitza Morales '24 presents Dr. Ogle and PRS faculty with the A Step Beyond award.
12 VIEW FROM THE RIDGE
We spoke to current students who have recently published books or participated in film festivals. Join us in celebrating the work of these accomplished Firebirds!



Arwan Shrivastava ‘25
Arwan’s short film, “Parallel Lives,” premiered at the San Diego Asian Film Festival. The short takes a look at the difficulties of being an immigrant in the United States, the never-ending desire for peace and overcoming the trauma of prejudice by embracing one’s own culture and beliefs.
“I focused predominantly on religion since it applies to many groups outside of my own. I found it interesting to talk about since it's a big part of my family's heritage. I also wanted to use the opportunity as a learning experience to get me out of my comfort zone and see how others responded to similar issues,” said Arwan. “As a filmmaker, my goal is to broaden the role of Asian Americans in Western media by building bridges through storytelling that brings understanding and dialogue into all spaces.”

Ethan Huntington ‘24
Ethan published a book, “Origami Alive!” this past fall. Ethan has been folding since he was seven years old and designing his own models since ninth grade. He hopes to continue making origami books and spreading awareness of the craft, and its benefits as not only a fun hobby, but one with potential in advancing technology
“I’ll be majoring in mechanical engineering in college. There are a lot of origami applications, especially recently in engineering and biomedical engineering. For instance, satellites, can now be made to sort of unfurl in space, they’re more space efficient,” says Ethan. “There are also medical applications, like medical devices that can be implanted in the body, and then they unfold. So this is something I like to explore more beyond just an art, but in college and maybe even my career.”

Shanti Hershenson ‘26
Teen author, Shanti Hershenson has written 29 books and published 16! She’s been creating stories since early childhood and published her first two novellas as a sixth grader. She writes in a variety of genres, including Science Fiction, Fantasy, and Contemporary, although she mostly sticks to SciFi. Shanti also advocates for antibullying and says you may find her doing volunteer work or performing powerful poetry at open mic nights.
“My all-time favorite author is Leigh Bardugo, I love the way she writes her characters. She inspires my writing and for the most part, I try to focus on my character development and how they grow through the story,” says Shanti. “I love the way a story comes to life because there’s always a point toward the end of the book when I realize how everything will connect. I don’t outline my books, so the ending feels like a surprise.”
Winter 2024 13
On October 28th, the Parents Association hosted Pacific Ridge School’s annual Fall Fest, an event to showcase student clubs, alliance groups, and service learning groups, and the roles each is serving across the school and in the community.


FALL FEST 2023
STUDENT-LED
SUPPORTING GROUPS AND CLUBS
Each year, this celebrated event fills the campus with booths of passionate students advocating for their projects and echoing the purpose that Pacific Ridge strives to instill within the student body.
This year, over 35 student-led clubs, affinity/alliance groups, and service learning groups presented their work and future opportunities for the community to be involved. Through engaging games, arts and crafts activities, and selling cultural food items, student groups raised over $8,000 for their service work and upcoming school presentations.
From the Asian Student Union selling boba to raise money for their school events to bring awareness to Asian culture, to SWENext offering witch’s brew to help empower girls in STEM through presentations and internships, students are offered a way to step into leadership and focus on causes and groups that are meaningful to them.
“Fall Fest offers clubs and service learning groups a place to promote all the amazing things we students do on campus. My service learning group, Global Vantage, got to sell Kenyan Chai to raise money for the senior retreat for KGSA.”
–Colton Mullen ‘24

The middle school came together to build a haunted house and carnival games, while the Parents Association put on a bake sale, a wine raffle, and helped seniors create their yearly pumpkin succulent sale. There were performances, food, and a myriad of ways to donate to different causes that the upper school students presented throughout the day.
Fall Fest is one of the many ways the entire community of Pacific Ridge comes together to create a positive impact in our community.
Through the school’s service learning program, Pacific Ridge offers students the tools and opportunities to participate in social change. Service learning allows students to learn about their relationships with the communities they wish to engage in, their capacity for serving others, cultural differences, and ultimately what it means to be a responsible citizen.
14 VIEW FROM THE RIDGE








“Service learning is an opportunity for students to step out of the academic checklist and develop who they want to be in their communities and how both students and adults on campus can identify the needs of that community and collaborate with local partners. Service Learning is as much about giving back as it is discovering what is gained when we participate.”
– Germaine Jackson, Director of Service Learning




Scan QR code to watch our video from Fall Fest
Winter 2024 15

MATH AT PRS:
Igniting a Passion for Problem Solving
“Thriving in math is not about how quickly you can arrive at answers or memorize algorithms, it's about the steps you take when you don't immediately know the answer to a problem,” says Amy Wasserman, chair of the PRS Math Department and founding faculty member.
This concept is fundamental to the math program at Pacific Ridge, where our student-centered, discoverybased curriculum motivates students toward mathematical inquiry. Students are encouraged to feel comfortable asking questions, making mistakes, and bouncing back with new ideas so that every student realizes their ability to problem solve.
“Our math program allows students to find connections between algebraic and geometric thinking, patterns, and problem solving. Students experience math in our classrooms by diving deep into the "why" of what we are studying,” says Wasserman. “From there, they
gain the confidence and skills to ask questions, explore, and demonstrate their knowledge. The result is that we have students who are analytical problem solvers willing to make mistakes, take risks, and want to learn more about the mathematics they see around them.”
Students’ voices in math classes are crucial. The more students grapple with mathematical concepts and relationships together, the more opportunity they have to better understand the mathematical principles involved.
Middle school math classes at PRS prepare students for their high school math experience by providing a solid algebraic and geometric foundation. The courses that middle school students typically take are Math Foundations, Introduction to Algebra, and Algebra/Geometry 1.
Our algebra/geometry sequence allows students to experience an integrated math curriculum where they see the connections in each course between
algebra, geometry, and finally trigonometry, in the third course of the algebra/geometry sequence. Once students have completed the sequence, they have the opportunity to explore precalculus and calculus, in addition to data science and statistics. Rounding out our math curriculum, our most advanced students can challenge themselves with accelerated courses on differential equations, multivariable calculus, and linear algebra.
Our curriculum is designed to help students view their math classes as a vehicle for becoming better problem solvers. Some students may see math as black or white or right or wrong, but one of the math program's primary goals is for students to take risks and attempt problems, learn from their mistakes, and build foundational skills that will help them persevere through their math classes.
“I have always been interested in math and have been in the advanced track for math at PRS,” says Ruby Belt ‘24. “But it was a constant struggle as I didn't understand the value of getting math problems wrong. PRS has taught me that all answers (even wrong answers) can teach you something. Being encouraged to present incorrect solutions has taught me that even if my answer is wrong, I always have something valuable to share. PRS has reignited my love for math.”
We support students as they do this by encouraging them to write their thoughts down and working with them in and out of class as they strengthen their foundational skills. In many of our advanced math classes, we are encouraging students to think on their own, utilizing lessons and activities as students work to discover mathematical theorems and proofs.
16 VIEW FROM THE RIDGE

We’d like to extinguish the idea that there is such a thing as a "math person" or a “non-math person.” Everyone does some kind of math, and everyone problem solves. The PRS math program builds confidence, provides challenge, and allows students to recognize that they can become great problem solvers.
I love that we are encouraged to present our math work, even if it is wrong, to help us strengthen our reasoning. I also love the focus on teamwork and building solutions as a class. My math classes have not only made me a better mathematician, but they also made me a more creative and critical thinker.
— Ruby Belt '24

Q & A WITH MS. WASSERMAN
What’s the equation for becoming a successful math student at PRS?
1) Be open to making mistakes and growing from them. 2 ) Be an active participant in class. 3) Always attempt all your homework and come to class ready to ask questions. 4) Be a self-advocate and reach out to your teachers when you don't understand something or you are struggling (though the teacher has probably already reached out to you if you are struggling). 5) Be up for a challenge! 6) When preparing for an assessment, redo problems that you originally found challenging in class and/or on your homework. 7 ) Focus more on growth in the class, rather than a grade – this will be far more effective as a lifelong learner of math!


Is there a math class you are really excited about this year? Or one you love to teach?
I love all my math classes! When I first started at PRS, I taught almost every math class we offered. This meant I taught both middle and upper school students for the first four years of the school. Then, for quite some time, I only taught high school math. It wasn't until last year, that I started teaching a middle school class again - I forgot how much I LOVE it! The students have so much energy and excitement, and it feels nice to focus on helping budding mathematicians build strong mathematical foundations. To be able to teach both book ends of our math program, namely Introduction to Algebra and AP BC Calculus, is an absolute pleasure that I look forward to continuing for the rest of my career.
Is there anything else you’d like to share?
We have an amazing math department. I love who I work with - it's my students and my colleagues that make me feel like I am living my professional dream!

Winter 2024 17
THE PARENTS ASSOCIATION: CULTIVATING COMMUNITY
Upcoming PA Events & Activities
LOOK FOR DETAILS IN UPCOMING EMAIL NEWSLETTERS!
FRIDAY, APRIL 19: Spring Parent Party
SPRING TBD: PA Board of Directors
Applications Open
THURSDAY, MAY 2: PA Parent Meeting: PRS Senior Reflections



From hosting grade-level parent parties to organizing Fall Fest, Gingerbread Breakfast and the Staff Appreciation luncheon -the Pacific Ridge Parents Association (PA) works hard to organize events that bring our community together.
All parents of Pacific Ridge School students are automatically members of the PA. The PA’s purpose is to support school programming, provide enrichment and social opportunities for parents, and help organize special school events – all of which enable families to stay connected to the school community.
Joining the PA Board or volunteering at one of our many events is a great way to engage in the life of the school and enhance our school community.


PA Events & Activities
PARENT SOCIALS
Welcome Coffee: Hosted on the first day of school as a great opportunity to meet or re-connect with parents
Fall Grade-Level Parties: Socials for all parents to get to know other families in their child’s grade
Parent Meetings: Held three times per year for parents to learn information from staff, alumni and students about school initiatives, programming and experiences
Supper Club: Small gatherings of parents who meet three to four times during the school year at a restaurant or a participant's home
Book Club: Meets four to six times per year to socialize and discuss books selected by the club
Hiking Club: Meets monthly with various hikes around North County
Yoga Club: Meets most Fridays to practice a healthy mind-body connection
Spring Parent Party: A fun party held the night before prom for parents to socialize and dance

SCHOOL & COMMUNITY SUPPORT
Used Uniform Sale: A parent-managed used uniform program hosting sales several times per year
Firebird Tailgates: Barbecues for students before athletic events, held several times per school year
PA-SPONSORED SCHOOL EVENTS
Fall Fest: An autumn-themed school festival at which students promote and raise funds for their service learning groups and clubs
Gingerbread Breakfast: PRS transforms into a winter wonderland for this annual event, which features student performances and brings together students, teachers and alumni the day before winter break
Staff Appreciation Lunch: A special meal held in the spring to celebrate and acknowledge school employees
HERE COMES THE SUN — Pacific Ridge Flips the Switch on Solar Energy

Charged with supporting Pacific Ridge School’s mission and protecting its future, the Board of Trustees began a search to provide solar energy at Pacific Ridge School. Our goal was to identify a plan that would control the costs the school will pay for electricity for at least the next 15 years, provide nearly all of the current power usage, and create a path to becoming a facility that utilizes 100% renewable energy.
And after working with Baker and DSD on the solar plan that worked with the needs of the school, on September 8th, Pacific Ridge School electrified our rooftop solar panels to complete a project more than two years in the making.
Once the system was operational, representatives from DSD Renewables and Baker Electric also joined service learning group Eco-friendly this year to educate students on the solar project and what it means for Pacific Ridge and a sustainable future.
Across Pacific Ridge School’s five buildings, Baker Electric installed 1,043 solar panels that are projected to generate over 723,000 kilowatt hours in the first year; or 86% of the projected annual electrical use.
According to the EPA calculator, every year the system is in operation, the environmental impact is equivalent to removing 114 vehicles from the road.
THANK YOU TO OUR COMMUNITY FOR SUPPORTING THE EFFORT, TO OUR FACILITIES AND CONSTRUCTION TEAMS FOR MAKING IT HAPPEN, AND TO OUR BOARD FOR THEIR FORESIGHT IN SEEKING OUT THIS OPPORTUNITY TO PROVIDE PACIFIC RIDGE WITH SUSTAINABLE ENERGY FOR THE FORESEEABLE FUTURE.


SUSTAINABILITY STARTS WITH SMALL STEPS:
Turn off lights when leaving a room
Keep temperature between 69-72 degrees
Unplug energy vampires when not in use
Winter 2024 19
6269
Hands-on
IMPORTANT DATES
MARCH 14 M iddle School Spring Snapshot
MARCH 23 Showcase of the Arts
APRIL 6 - 14 Spring Break
APRIL 19 Parent Party
APRIL 20 Prom
APRIL 25 - 27 Upper School Musical Performance
MAY 2 Upper School Awards
MAY 25 - JUNE 9 G lobal Travel Period
JUNE 11 8 th Grade Promotion & Middle School Awards
JUNE 13 C ommencement

6
7
8
9
10
11
PACIFICRIDGE.ORG | 760-448-9820 © 2024 Pacific Ridge School. All Rights Reserved
th GRADE Outdoor adventures in Pali Mountain
th GRADE Marine biology and stewardship in Catalina Island
th GRADE Understanding U.S. government in Washington, D.C.
th GRADE Teamwork and leadership in Arizona’s Coconino National Forest
th GRADE Immersive exploration in Costa Rica
of
Immersion in the Land of the Blue Dragon GLOBAL TRAVEL PROGRAM SPRING 2023: GLOBAL TRAVEL PROGRAM SPRING 2024:
th & 12 th GRADE Croatia: Sailing adventure on the Adriatic Sea; Czechia & Austria: Arts & Advocacy in Central Europe; The Galapagos Islands: Biological Wonderland; Japan: Technological Innovation in the Land of the Rising Sun; Namibia: The “Place
No People”; Patagonia: Outdoor Adventure; Vietnam: Cultural
El Fuerte Street Carlsbad, CA 92009
3 and up PACIFIC RID GE SCHOOL EXPLORE WITH US
Camps Academic Enrichment Courses Interactive Workshops For Grades